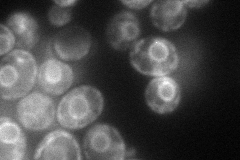
YFR041C
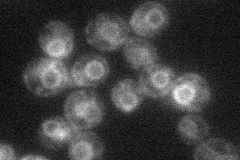
YFR041C
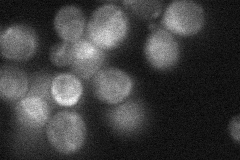
YFR041C
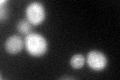
YFR041C

View description
Type I membrane protein with a J domain is required to preserve the folding capacity of the endoplasmic reticulum; loss of the non-essential ERJ5 gene leads to a constitutively induced unfolded protein response
Localization:
Intensity:
Fold change:
Significance:
-
C’ GFP library in SD

ER33.09 -
N' NOP1pr-GFP in SD
ER82.6288 -
N' TEF2pr-mCherry in SD
ER26.1251 -
N' NATIVEpr-GFP in SD
ER30.9486 -
N' TEF2pr-VC and Cyto-VN in SD

#N/A0 -
C’ GFP library in SD+DTT
ER56.951.72Yes -
C’ GFP library in SD+H2O2

ER33.531.01No -
C’ GFP library in Starvation Media

ER27.980.84No -
C’ GFP library on the background of Pup2-DaMP

ER -
C’ GFP library on the background of CCT mutant

ER30.15980.911329No
